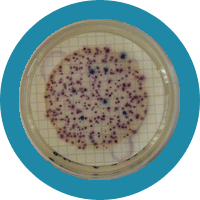

Documentos recientes
Documentos recientes |  Descargas
Descargas
Actividades Actividad 1 Propuesta de implantación de sistemas de gestión y de información a los usuarios de las zonas de baño de la Macaronesia europea. Actividad 2 Estudio para la designación de nuevas zonas de baño. Actividad 3 Difusión y promoción de actividades y resultados. Actividad 4 Técnicas de identificación de hongos en arenas y validación de análisis microbiológicos en agua de mar. Actividad 5 Estudio de la calidad sanitaria de arenas en playas. Actividad 6 Modelo de simulación de plumas de emisarios de aguas residuales con el objeto de evaluar y predecir los riesgos potenciales de contaminación en zonas costeras y de baño. Actividad 7 Evaluación de sistemas de alarma para estaciones de bombeo de aguas residuales y su aplicación a la Macaronesia. Actividad 8 Propuestas de optimización del saneamiento urbano y recomendaciones para el tratamiento de las aguas residuales en núcleos diseminados y establecimientos hoteleros del litoral. Actividad 9 Evaluación de tecnologías a partir de proyectos piloto demostrativos de depuración a pequeña escala para núcleos diseminados y establecimientos hoteleros del litoral. Actividad 10 Desarrollo de un Sistema de Información y de un Asesor Inteligente para la selección y utilización de tecnologías de tratamiento de aguas residuales para la Macaronesia europea. Actividad 11 Jornadas municipales de gestión y tratamiento de las aguas residuales en núcleos diseminados de la Macaronesia europea y publicación de resultados. Actividad 12 Evaluación de contaminantes específicos en aguas costeras de la Macaronesia europea. Actividad 13 Evaluación del efecto de los efluentes procedentes de la escorrentía superficial, del tratamiento de aguas residuales y de la desalación, sobre la calidad de las aguas costeras. PRESENTACIONES DE LAS JORNADAS FINALES DE DIVULGACIÓN DE RESULTADOS (13 y 14 DE DICIEMBRE DE 2012)
|



 OBJ5.Evalución concentración de contaminantes especificos en el litoral canario.pdf
OBJ5.Evalución concentración de contaminantes especificos en el litoral canario.pdf